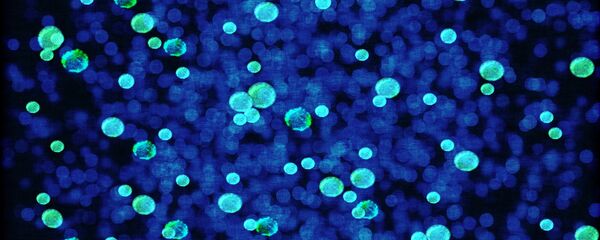
Bactérie Bactérie - Sputnik Afrique

Les bactéries résistantes aux antibiotiques ne reçoivent pas autant d'attention que le Covid-19, car les maladies qu'elles provoquent se propagent lentement plutôt que de prendre d'assaut le monde en peu de temps. Cependant, elles pourraient devenir une menace non moins grave que le Covid-19, prévient la revue Science Alert.
Selon les Centres pour le contrôle et la prévention des maladies (CDC), agence américaine en matière de protection de la santé publique, près de trois millions d'Américains contractent chaque année une infection bactérienne résistante aux antibiotiques et environ 35.000 d'entre eux meurent.
À l'origine de maladies impossibles à traiter
Ces chercheurs estiment qu'en raison de la surutilisation d'antibiotiques, de nombreux types d'infections bactériennes, y compris les souches de gonorrhée, de la tuberculose et de la salmonelle, sont devenues extrêmement difficiles, voire impossibles, à traiter. Une petite partie des bactéries qui survit à ces antibiotiques évolue et se reproduit, développant une résistance.
Steffanie Strathdee, professeur de médecine à l'université de Californie à San Diego, estime que la menace des superbactéries n'est pas suffisamment évoquée.
«Contrairement au Covid-19, qui est arrivé soudainement et a éclaté sur les lieux, la crise des superbactéries a mijoté. C'est déjà une pandémie. C'est déjà une crise mondiale, et ça empire avec le Covid», assure-t-elle.